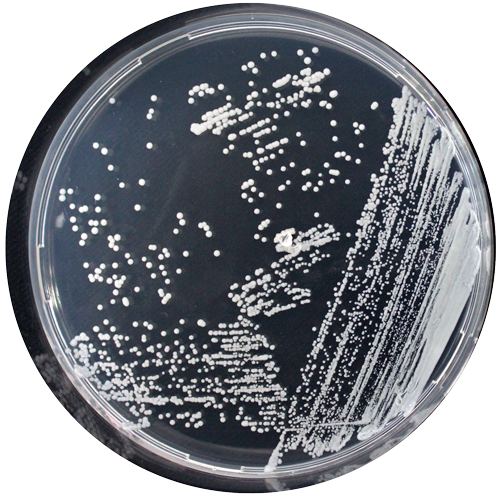
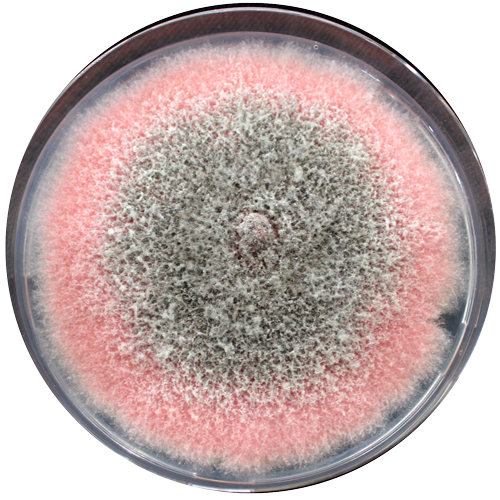
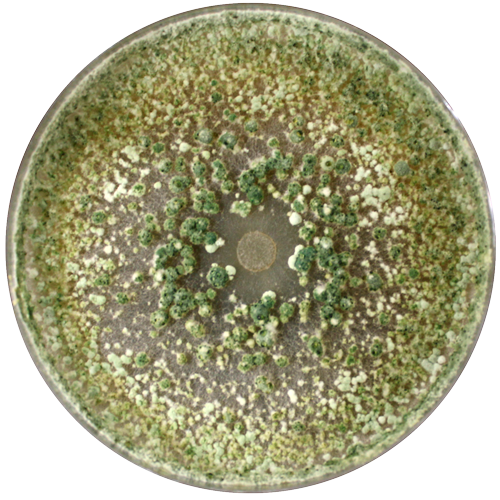
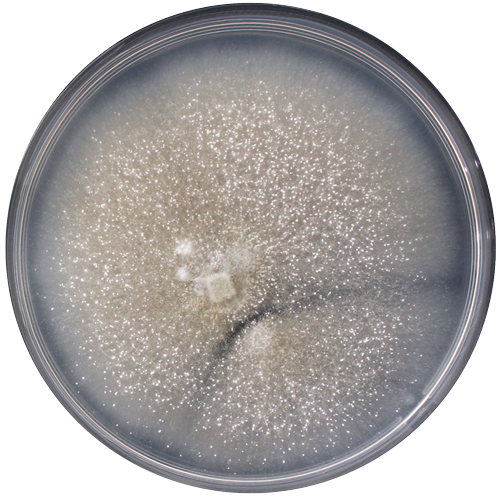

Banco de Recursos Genéticos Microbianos (BRGM)
La Colección Chilena de Recursos Genéticos Microbianos (CChRGM) es una Autoridad Internacional de Depósito (IDA), ubicada en el Banco de Recursos Genéticos Microbianos del INIA.


Conservar, estudiar y valorizar los microorganismos presentes en Chile
La Colección Chilena de Recursos Genéticos Microbianos (CChRGM) nace como parte de una misión estratégica del INIA: conservar, estudiar y valorizar los microorganismos presentes en Chile. Hoy, esta colección no solo preserva la diversidad microbiana del país, sino que es también una plataforma clave para la ciencia, la innovación y la propiedad intelectual en todo Chile y Sudamérica.
Historia
Nuestros principales hitos
- 1997: Nace la CChRGM en INIA Quilamapu, como resultado de colectas realizadas por investigadores en terreno.
- 2011: Entra en vigencia en Chile el Tratado de Budapest, que permite el reconocimiento internacional de depósitos microbianos con fines de patentamiento.
- 2012: El 26 de marzo, la CChRGM se convierte en la primera Autoridad Internacional de Depósito (IDA) de América Latina, reconocida por la OMPI (Notificación Budapest N° 283).
- 2013: Se inaugura la primera etapa del Banco de Recursos Genéticos Microbianos (BRGM).
- 2014: La colección se incorpora a la World Federation for Culture Collections (WFCC), con el código 1067.
- 2017: Se inaugura la segunda etapa del BRGM, dando forma al actual edificio, ampliando capacidad e infraestructura.
- 2023: Se lanza la Plataforma de Preservación de Recursos Genéticos, fortaleciendo la conservación y trazabilidad. Esto gracias a la adquisición de un generador de nitrógeno líquido y de un liofilizador para sistema de ampollas de vidrio.
Una colección con respaldo internacional
El BRGM representa un esfuerzo articulado entre los Ministerios de Economía, Agricultura y Relaciones Exteriores de Chile, para cumplir con estándares internacionales en materia de conservación, distribución y acceso a recursos genéticos, alineados con los lineamientos de la OCDE y el Tratado de Budapest.
Gracias a ello, la CChRGM se consolidó como la primera y única IDA de Sudamérica, autorizada para recibir microorganismos con fines de patentamiento internacional, brindando respaldo técnico y legal a investigadores, universidades y empresas innovadoras.

De las colectas al laboratorio: ciencia con impacto
Las actividades de recolección y estudio de microorganismos realizadas entre 2006 y 2009, en colaboración con el Centro Internacional de Agricultura y Biociencias (CABI) de Reino Unido, permitieron identificar cepas con potencial como biopesticidas. Financiadas por The Darwin Initiative, estas investigaciones impulsaron el desarrollo de alternativas sustentables a los pesticidas químicos en cultivos agrícolas.
El resultado: varios de estos microorganismos pasaron de la colección a convertirse en productos tecnológicos de uso agrícola, comercializados bajo la marca BioINIA siendo producidos por el Centro Nacional de Bioinsumos (CeNBI) del INIA Quilamapu.
El resultado: varios de estos microorganismos pasaron de la colección a convertirse en productos tecnológicos de uso agrícola, comercializados bajo la marca BioINIA siendo producidos por el Centro Nacional de Bioinsumos (CeNBI) del INIA Quilamapu.
Infraestructura para la biotecnología
La ampliación del BRGM en 2017 significó una inversión clave para fortalecer sus capacidades. Hoy, el edificio cuenta con cuatro modernos laboratorios, en los que se lleva a cabo tanto investigación como valorización de los microorganismos conservados en la CChRGM, transformando recursos genéticos en soluciones biotecnológicas aplicadas para la agricultura chilena e internacional.

Laboratorio de Identificación Molecular (LIM)
Identificación precisa para la conservación y uso seguro de microorganismos.

Laboratorio de Microbiología Aplicada (LMA)
Diagnóstico fitopatológico de precisión para la salud de los cultivos

Laboratorio de Bioprocesos
(LBP)
(LBP)
Desarrollo de soluciones basadas en microorganismos para una agricultura sustentable.
Un referente nacional y sudamericano
Desde su primer depósito oficial como IDA en 2013, la CChRGM ha recibido microorganismos en todas las categorías: públicas, privadas y para fines de patentamiento. Su experiencia, reconocimiento y rol articulador entre ciencia, innovación y desarrollo la posicionan como un referente en conservación microbiana en Chile y Sudamérica.